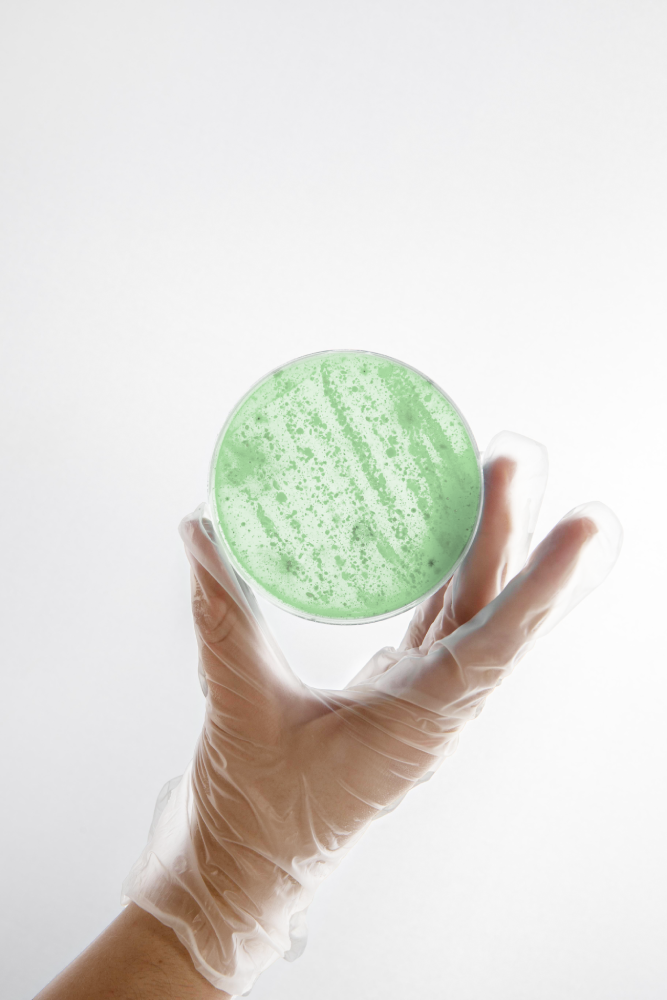

Lacticaseibacillus rhamnosus B/00379 – unikalny szczep z mleka matki
B/00379 to wyjątkowy szczep probiotyczny, wyizolowany z mleka matki.
Naturalny, skuteczny i bezpieczny – wspiera barierę ochronną skóry i organizmu. To przełomowe odkrycie pozwala korzystać z dobroczynnych właściwości mleka matki także w dorosłym życiu. Wspiera odporność, łagodzi stany zapalne i pomaga utrzymać zdrowy mikrobiom skóry i jelit.

Jak powstała idea?
Mleko matki to pierwszy naturalny probiotyk, który wspiera odporność i rozwój dziecka od pierwszych dni życia. W Lactee Laboratories postanowiliśmy przenieść jego wyjątkowe właściwości do nowoczesnej pielęgnacji i wsparcia mikrobiomu. Zależało nam na stworzeniu rozwiązania, które będzie nie tylko skuteczne, ale też łagodne i zgodne z biologią człowieka. Dlatego sięgnęliśmy do najczystszego źródła – natury.
Ponad 2000 szczepów,
jeden wyjątkowy
Po 6 latach intensywnych badań nad tysiącami szczepów probiotycznych, wyselekcjonowaliśmy ten jeden – Lacticaseibacillus rhamnosus B/00379. To szczep, który doskonale przystosowuje się do warunków panujących w organizmie człowieka, nie wykazuje oporności na antybiotyki i aktywnie wspiera naturalną barierę ochronną skóry. Dzięki zaawansowanej technologii udało się zachować jego pełną aktywność biologiczną. Nasz unikalny szczep przeszedł szczegółowe badania in vitro w modelach 2D oraz 3D komórek skóry, udowadniając brak cyto- oraz genotoksyczności na komórki.

Skuteczność udowodniona naukowo
Nasz unikatowy szczep wykazuje potwierdzone w badaniach działanie ochronne wobec mikroflory organizmu. Redukuje ponad 80% patogenów, wspierając naturalne mechanizmy obronne w obszarach takich jak skóra, układ moczowo-płciowy oraz przewód pokarmowy. Jego działanie obejmuje również stabilizację mikrobiomu w warunkach stresu, osłabienia odporności lub zaburzeń równowagi bakteryjnej.
Kazdy nasz kosmetyk przechodzi badania in vitro na modelach skóry 3D, oraz badania in vitro w laboratoriach akredytowanych (badania aplikacyjne na ochotnikach).
Badania
Za każdą recepturą stoi proces – od selekcji składników po laboratoryjne potwierdzenie ich działania. Korzystamy z aktualnej wiedzy naukowej i prowadzimy testy, które pozwalają ocenić realny wpływ naszych formuł na organizm. To dzięki temu mamy pewność, że oferujemy produkty skuteczne, bezpieczne i zgodne z fizjologią człowieka.
Szczep probiotyczny L.rhamnosus B00379 w celu identyfikacji został poddany sekwencjonowaniu pełnego genomu w Biobanku Uniwersytetu Łódzkiego oraz sekwencjonowaniu MALDI w Zakładzie Immunologii Chorób Zakaźnych, Instytut Immunologii i Terapii Doświadczalnej PAN (Polskiej Kolekcji Mikroorganizmów). Dzięki współpracy z IBB PAN w Warszawie, przebadaliśmy również płyn, po hodowli bakterii probiotycznych w celu określenia ilości i jakości substancji będących metabolitami bakteryjnymi. Bakterie wydzielają związki przeciwdrobnoustrojowe, przeciwwirusowe, przeciwzapalne, witaminy i peptydy, które pozytywnie wpływają na jakość i skuteczność naszych kosmetyków.


Skóra
Redukcja ilości bakterii patogennych Staphylococcus epidermidis
77,1%
Niwelowanie problemów skórnych:
atopowe zapalenie skóry
łojotokowe zapalenie skóry
zmiany trądzikowe
wykwity pod skórą
zmiany ropne, owrzodzenia


Jelita
Redukcja ilości bakterii patogennych Escherichia coli
84,3%
Niwelowanie problemów związanych z układem pokarmowym:
biegunka podróżnych
zakażenia układu pokarmowego
zatrucia pokarmowe








